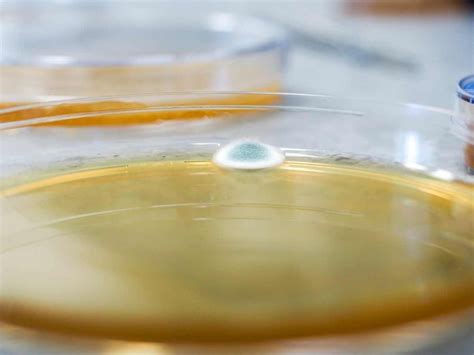
Kontaminace vajec

Toxická vejce: Celosvětový problém kontaminace a ohrožení zdraví
Kontaminace vajec toxickými látkami představuje vážný celosvětový problém s potenciálními dopady na lidské zdraví a životní prostředí. Studie a kontroly odhalují přítomnost nebezpečných látek ve vejcích z různých koutů světa, včetně Evropy.

Nebezpečný fipronil v evropských vejcích
Obchody v Nizozemsku, Belgii a Německu stahovaly z prodeje miliony vajec, která obsahovaly toxický fipronil - látku, která se používá k likvidaci vší, klíšťat a blech. Člověku může poškodit játra, ledviny nebo štítnou žlázu. Jeho množství je dle úřadů nebezpečné pro děti.
Dvě značky insekticidu, jehož některé šarže obsahovaly účinnou látku fipronil s vysokým toxickým potenciálem, jsou na trhu vedle Belgie a Nizozemska také ve Francii, Itálii, Německu a Polsku.
Veterináři v Česku začali namátkově kontrolovat vejce a kuřecí ze šesti zemí, kde se v chovech mohl nebezpečný insekticid používat. Vejce z Belgie byla podle veterinární správy na českém trhu naposledy v dubnu a vejce z Nizozemí naposledy v květnu. Kuřecí maso z Belgie se v Česku naposledy objevilo v červnu.
Varování dostaly také všechny členské státy Evropské unie. Česká Státní veterinární správa provádí podle mluvčího Petra Majera namátkové kontroly vajec z dotčených zemí. Z Belgie a Nizozemska se ale podle správy v posledních měsících vejce do Česka nedovážela.
Původcem zamoření nizozemských vajec insekticidem mohl podle vyšetřovatelů být výrobce chemikálií ze severu Belgie. Jeho firma dodala dezinfekční prostředek s jedovatým fipronilem drůbežárnám, odkud se kontaminovaná vejce dostala do prodeje.
Německý časopis Spiegel s odvoláním na vyšetřovatele uvádí, že si belgický podnikatel nebezpečný insekticid obstaral na přelomu roku v jedné rumunské továrně. Podle jeho společníka šlo o dodávku v hodnotě milionů korun.
Látka používaná k hubení blech, vší a klíšťat byla pak nepovoleně přimíchána do dezinfekce pro nizozemské drůbežárny. Fipronil se totiž nesmí používat u zvířat určených ke konzumaci. Podle lékařů může u lidí poškodit játra, ledviny nebo štítnou žlázu. U dospělých je škodlivý až při větším množství. U dětí ale stačí i nízká dávka.
Nizozemské úřady kvůli výskytu jedovaté látky ve vejcích dočasně zavřely 180 drůbežáren.
Belgické úřady věděly o podezření na kontaminovaná vejce látkou fipronil už začátkem června, informovaly o něm ale poprvé až 20. července. Potvrdil to v sobotu agentuře DPA belgický úřad pro kontrolu potravin.
Pokud jíte každý den 4 vejce, toto se stane s vašimi cévami! – 6 skutečných účinků
Dioxiny a další POPs ve vejcích z celého světa
Vejce z pěti kontinentů obsahují vysoké koncentrace celosvětově zakázaných zpomalovačů hoření a bromovaných dioxinů - chemických látek, o jejichž regulaci bude tento týden jednat expertní komise Stockholmské úmluvy. Nová studie publikovaná v časopise Emerging Contaminants přináší znepokojivá zjištění o kontaminaci potravin toxickými látkami.
Arnika na zasedání stran Stockholmské úmluvy prezentuje výsledky nedávno provedených analýz slepičích vajec z 29 zemí na přítomnost dioxinů a jim podobných látek. Vejce volně žijících slepic jsou indikátorem znečištění životního prostředí perzistentními organickými polutanty (POPs) a dalšími toxickými látkami.
Nejhorší situace panuje v Ghaně, kde vejce z okolí skládky elektronického odpadu obsahovaly bromované dioxiny v koncentraci 503 pg TEQ/g tuku - což je dvěstěkrát více než povoluje bezpečnostní limit pro potraviny stanovený pro příbuzné chlorované dioxiny.
Extrémních hodnot dosáhly i analyzovaná vejce z Kazachstánu, kde vědci naměřili koncentraci více než 18 000 ng/g tuku hexabromcyklododekanu (HBCDD) - nejvyšší hodnotu, která kdy byly na světě pro tuto látku ve vejcích zaznamenána.
Chutný oběd: Gratinovaná vejce
Čtvrtou nejvyšší koncentraci HBCDD ve sledovaných vejcích, přes 4 600 ng/g tuku, pak vědecká studie našla ve vzorku vajec z Pitárného v České republice. Kontaminace vajec nejspíš pochází z použití této látky v polystyrenu pro tepelnou izolaci budov.
Bromované zpomalovače hoření a bromované dioxiny nalezené ve vejcích jsou spojeny se závažnými zdravotními dopady, včetně narušení endokrinního systému, reprodukční toxicity, poruch neurologického vývoje, poškození imunitního systému a rakoviny.
Studie odhalila, že vejce z oblastí poblíž lokalit elektronického odpadu, skládek a spaloven odpadů jsou vážně kontaminována bromovanými dioxiny (PBDD/Fs) a bromovanými zpomalovači hoření (BFRs), čímž představují významný zdroj expozice lidí těmto toxickým látkám.
Tyto škodlivé látky se běžně nacházejí v plastovém elektronickém odpadu a uvolňují se při spalování plastů na skládkách nebo ve spalovnách. Následná environmentální kontaminace umožňuje slepicím ve volném chovu přijímat tyto toxické látky vázané na drobné částice půdy a prachu anebo v půdě žijících živočiších a přenášet je do vajec, které poté konzumují lidé.
Autoři studie zdůrazňují, že kontaminovaná vejce nejsou pouze environmentálním signálem, ale představují přímý problém veřejného zdraví. Na základě alarmujících zjištění vyzývají k okamžitým opatřením na globální úrovni.
Celkem tak Arnika a IPEN prezentují srovnání výsledků ze 47 lokalit v devětadvaceti zemích po celém světě analyzovaných v letech 2004 až 2018. Srovnáním vysokého počtu vzorků chtějí poukázat na vážné mezery v mezinárodní legislativě.
Kromě Stockholmské úmluvy o persistentních organických polutantech jednají delegáti v Ženevě také o Basilejské úmluvě.
Tabulka: Kontaminace vajec v různých zemích
| Země | Kontaminant | Koncentrace |
|---|---|---|
| Ghana | Bromované dioxiny | 503 pg TEQ/g tuku |
| Kazachstán | Hexabromcyklododekan (HBCDD) | >18 000 ng/g tuku |
| Česká republika (Pitárné) | Hexabromcyklododekan (HBCDD) | >4 600 ng/g tuku |
Další případy kontaminace vajec
Státní veterinární správa vyhlásila rozsáhlé stahování vajec z trhu. Důvod? V laboratořích našli v jedné várce téměř čtyřnásobné překročení limitu antibiotika monensinu. Místo povolených 2 mikrogramů na kilogram naměřili rovných 7,4.
Závadná vejce poznáte podle označení 3-CZ-0302 vytištěného přímo na skořápce. Jde o produkci z období od 9. do 26. června letošního roku. Celkem putuje zpět k výrobci neuvěřitelných 239 310 kusů.
Podle SVS patří Monensin mezi takzvaná ionoforová antibiotika. Farmáři ho běžně přidávají do krmiva pro drůbež. Chrání slepice před kokcidiózou, parazitární nemocí střev. Jenže ve vejcích nemá co dělat. Už vůbec ne v takovém množství.
„Při náhodné expozici může způsobit závratě, slabost, poškození svalů a srdce, nevolnost nebo zvracení,“ vypočítává možné následky mluvčí SVS.
Veterináři prošetřují, jak se antibiotikum dostalo do vajec v tak vysoké koncentraci. Firma AGRI-M má zakázáno prodávat jakákoliv další vejce. Dokud neprokáže, že nová produkce je v pořádku, zůstávají její slepice v karanténě.
Lidé v Nizozemsku by měli přestat jíst vejce z domácího chovu kvůli kontaminaci látkami PFAS, které se označují jako „věčné chemikálie“, oznámila minulý týden nizozemská vládní agentura. Národní institut pro veřejné zdraví a životní prostředí (RIVM) varoval, že vejce nekomerčního původu - tedy vejce od slepic chovaných soukromě, a nikoli zakoupená v obchodech nebo na trzích - mohou obsahovat vysoké množství PFAS.

